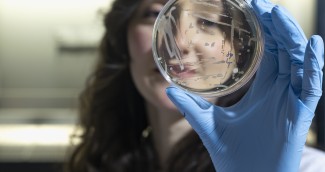

Labore sehen, Welt verstehen: MiniNOI für junge Technikfans.
Unser Aktionsfeld? International. Unsere Emotionen? Verwurzelt in der Südtiroler Gesellschaft. Mit Events, Workshops und Führungen binden wir die Menschen der Region ein. Immer wieder entstehen spannende Ideen genau an diesen Schnittpunkten. NOIs Investition in die Zukunft: MiniNOI. Wir machen aus Kindern und Jugendlichen neugierige Erwachsene. Mit Robotik, Elektronik, Programmierung.